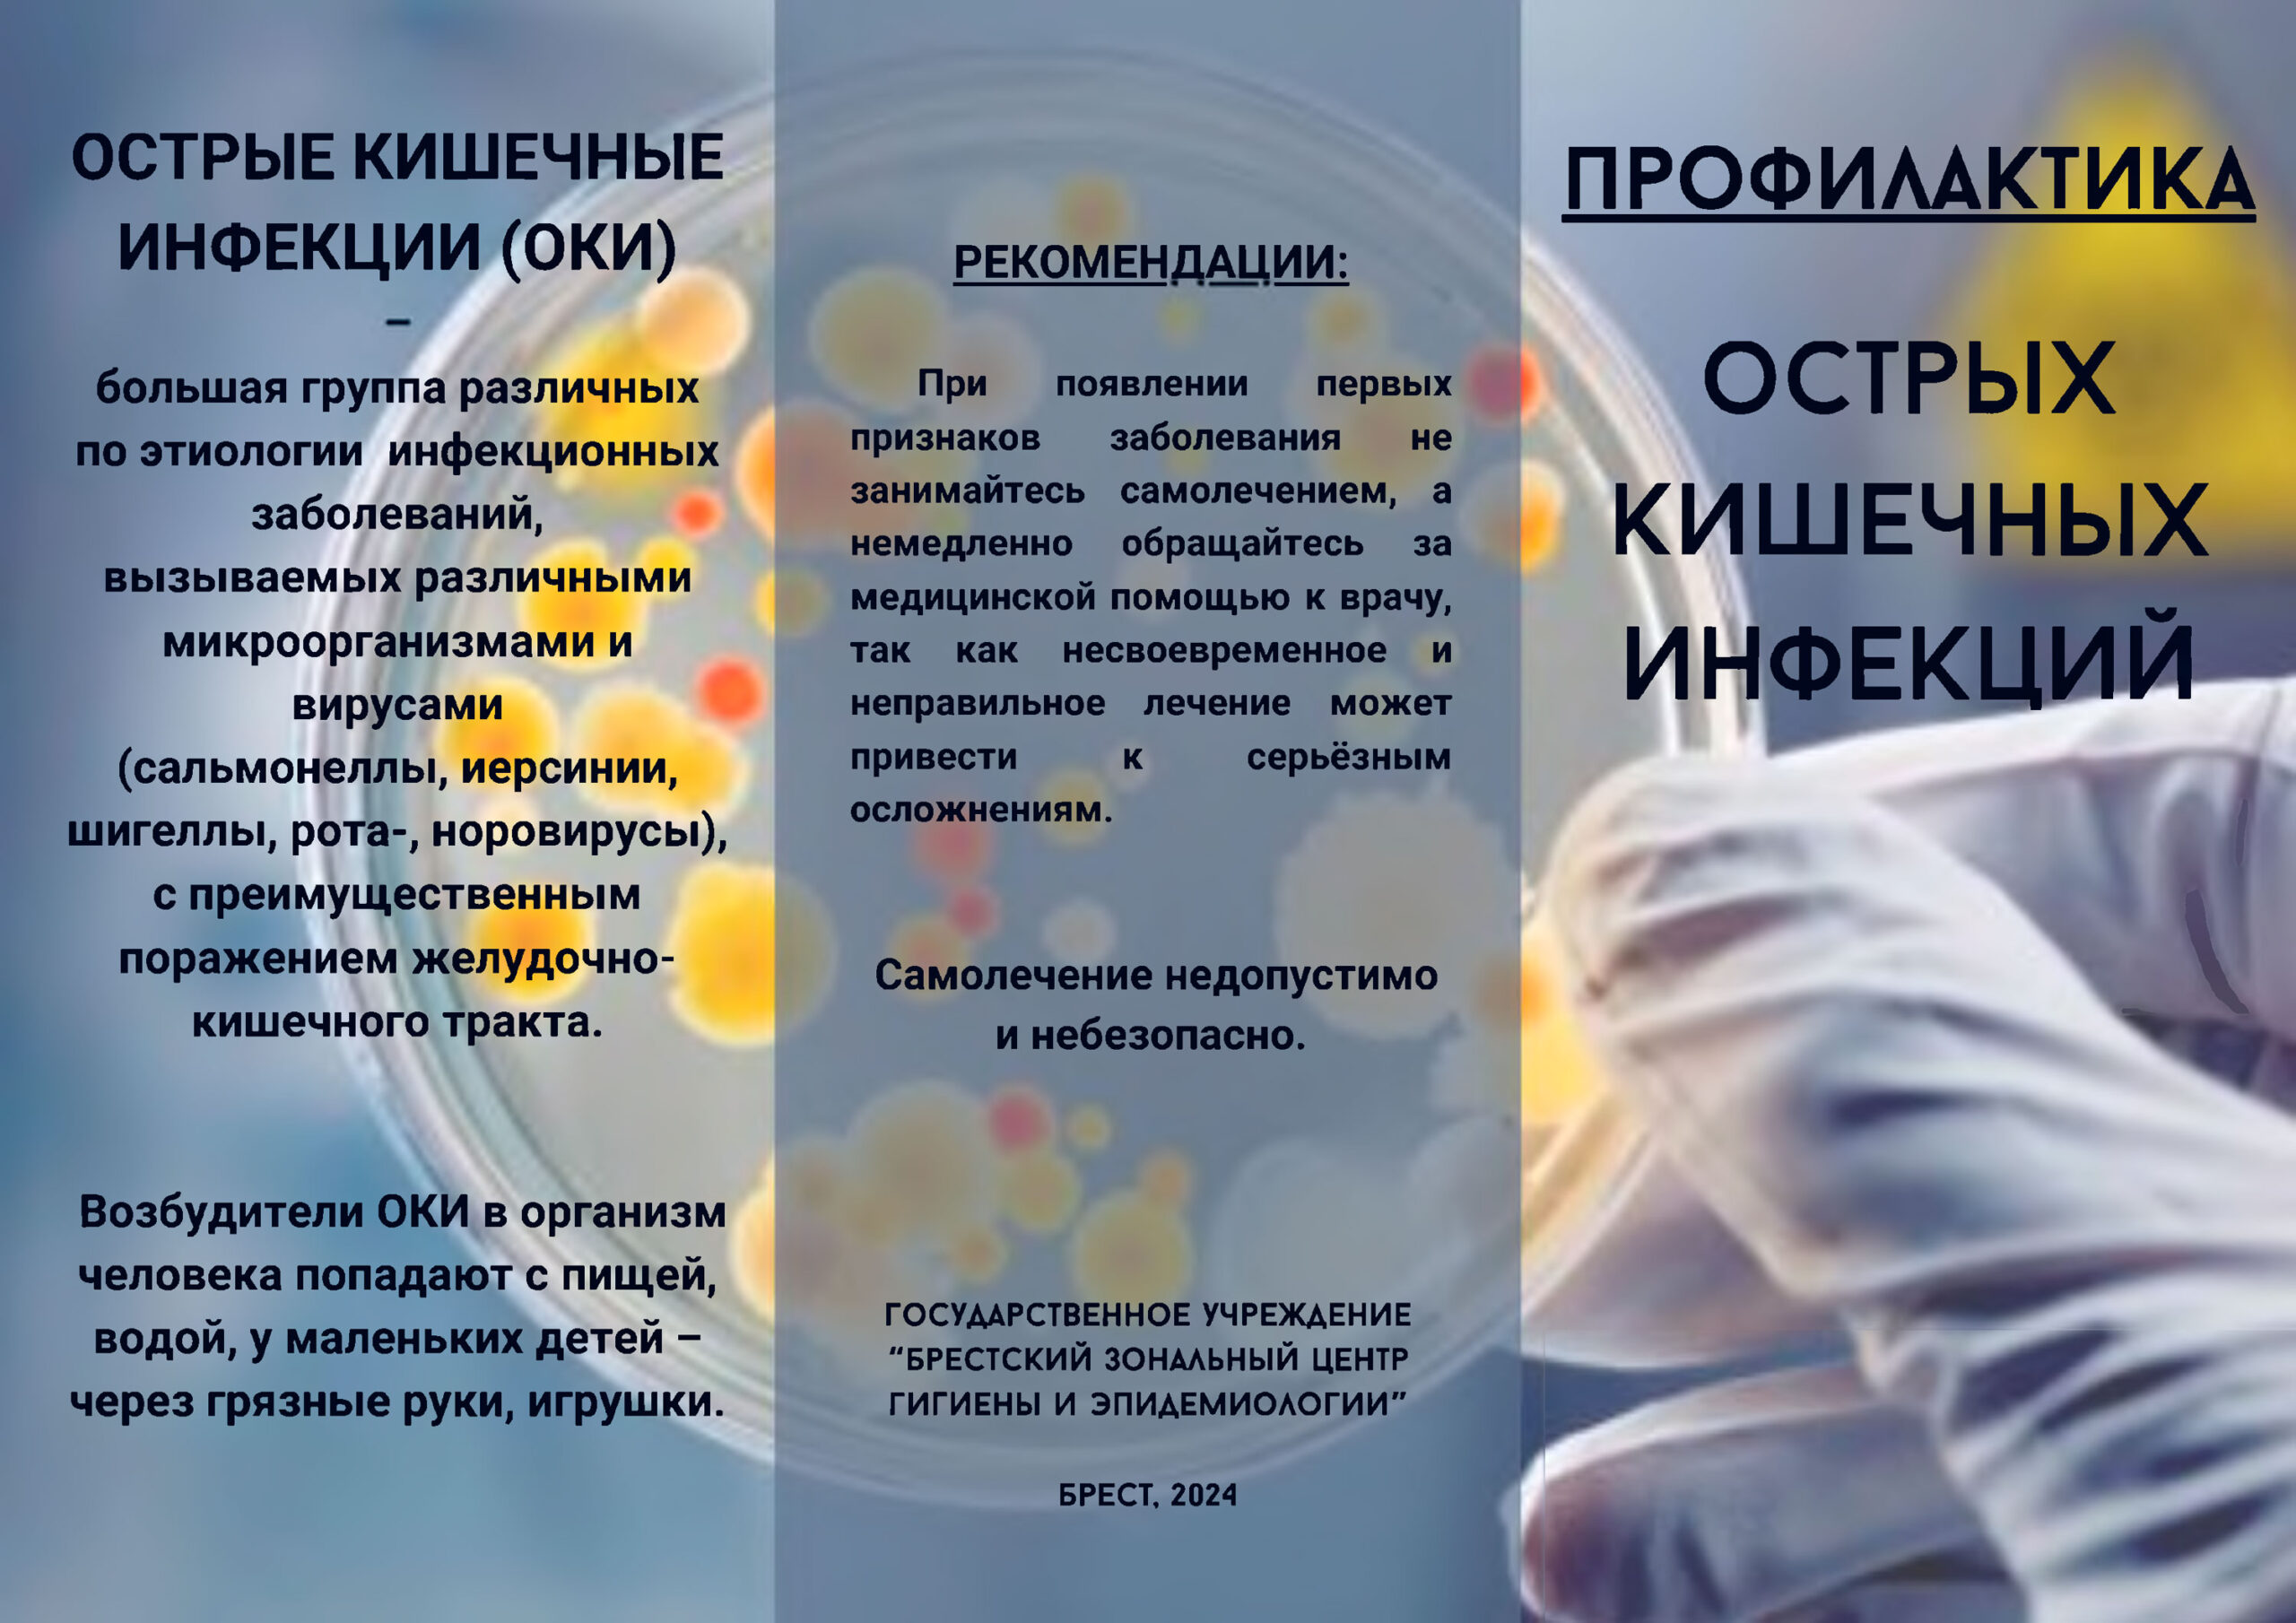

Телефоны регистратуры
Взрослая регистратура
8 (0162) 50-92-90Вызов врача на дом
8 (0162) 58-82-67
8 (0162) 58-82-67
Детская регистратура
8 (0162) 50-92-25
8 (0162) 23-66-06
8 (0162) 50-92-25
8 (0162) 23-66-06
Запись на стоматологический прием
8 (0162) 50-92-90
8 (0162) 50-92-90
Запись на стоматологический прием (детский)
8 (0162) 50-92-25
8 (0162) 50-92-25
Русский


